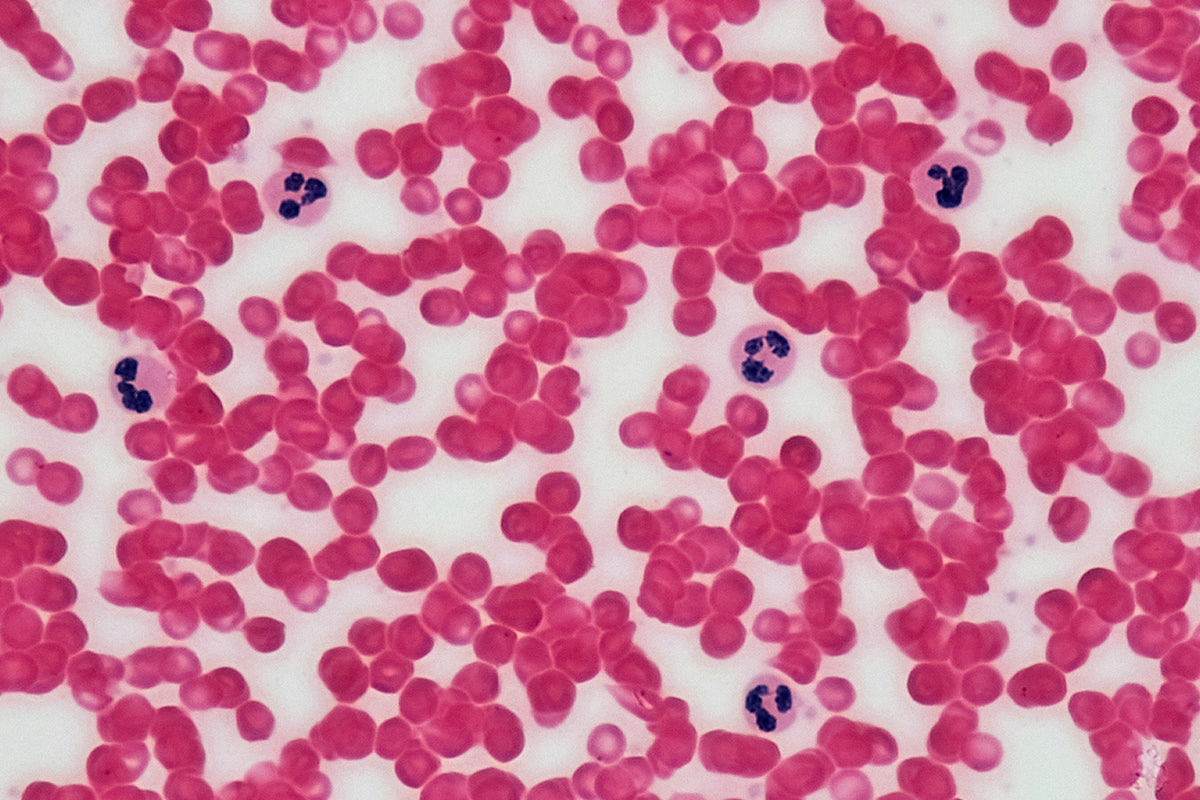

Open Letter
My name is Wesley Cooke and I am the founder of Nutrition Lab Sciences.
I am writing this letter to outline a vision for a healthier, more resilient humanity—one that I believe is both necessary and possible—grounded in a new nutritional science we call Phytobiogenics. This is not a small optimisation of our current systems; it is a structural change in how we think about food, symptoms, and human biology.
We stand at a pivotal moment in history. Our global food and health systems are failing to deliver what human biology actually needs. The very things that should sustain, nourish, and repair us—our food and environment—have been degraded, leaving billions undernourished at the cellular level while chronic, lifestyle-driven disease continues to rise.
What is unfolding is not only a micronutrient problem. It is a quiet global nutrient collapse—the erosion of nutrient density, minerals, amino acids, co-factors, and bioactive signalling compounds, compounded by declining bioavailability.
Our systems are not designed to reverse this trend. They simply manage the outcome.
A global awakening is unfolding as we recognise a crisis in our collective health. Nearly everyone knows someone who is chronically ill—often within their own family. Over recent decades, chronic illness has been normalised while the health system profits trillions, yet we grow sicker each year. In addition, our individual health impacts future generations in our family in ways we are just starting to understand. People are beginning to ask the right questions and seek real answers from the governments and industries that have a duty to serve and protect us.
It is vital that we change the outcome of this story and reverse these global trends.

Food System
Our food system, once a source of life, is now riddled with issues. The soil, depleted of nutrients, yields crops that are mere shadows of the foods our ancestors relied on. The rise of genetically modified organisms (GMOs), combined with the widespread use of herbicides and pesticides, has introduced foreign substances into our food supply, compromising the quality and integrity of the nutrients within. As our food has become less nourishing, the burden on our health has only grown. The modern world has become highly efficient at producing calories—and increasingly unreliable at delivering the biological inputs that govern human function.
- Nearly 33% of the world’s soil is degraded due to unsustainable farming practices.
- More than 70% of processed foods contain genetically modified organisms (GMOs).
- Hundreds of millions of tons of herbicides, pesticides and fertilisers are applied annually, contaminating our soil, air, and water.

Health System
Our health system, too, is in crisis. Chronic diseases such as heart disease, diabetes, and cancer are at record highs. Antibiotics, although sometimes vital, are now overprescribed—creating resistant bacterial strains and weakening natural immunity. Environmental toxins infiltrate our air, water, and even the spaces we occupy, contributing to an unseen toll on our bodies. Together, these factors have created a feedback loop of declining health and lost resilience. Modern healthcare excels at intervening in acute failure, but it is structurally unequipped to rebuild the upstream biological terrain—so it manages symptoms where inputs have collapsed.
- Globally, $1.4 trillion is spent annually on pharmaceutical medications.
- Each year, over 1.6 billion Disability-Adjusted Life Years (DALYs) are lost to chronic conditions or non-communicable diseases (NCDs).
- According to the World Health Organization (WHO), 74% of all global deaths result from NCDs—over 41 million lives lost every year.

Global Health Landscape
Recent global analyses from the WHO, FAO, UNICEF, and the Micronutrient Forum reveal that the scale of global nutrient collapse is far greater than previously recognised.
Earlier estimates that "over 2 billion people" suffer from at least one micronutrient deficiency are now known to be conservative. New modelling published in The Lancet Global Health (2022) and GAIN Global Reports (2023–2024) indicates that more than half the world’s population — approximately 4 billion people — are consuming inadequate levels of critical micronutrients. But micronutrients are only the most measurable signal within a wider collapse—including minerals, amino acids, co-factors, and bioactive signalling compounds—and the growing problem of bioavailability.
Deficiency-related undernutrition contributes to nearly half of all child deaths and impairs immunity, cognition, and longevity in adults, creating a hidden burden that spans all regions and income levels.
When viewed alongside the global rise in non-communicable diseases—now affecting over 3.5 billion adults—it becomes clear that the world faces a convergent crisis: nutrient collapse, chronic disease, and rising toxic burden. All three share a common root cause: the loss of access to essential biological inputs—and the declining ability of the human body to absorb and utilise what remains.
Together, these interlinked conditions represent the single greatest driver of preventable disease, disability, and economic loss—a crisis measured not just in dollars or data, but in the erosion of human potential and vitality.

The Loss of our Natural Ability to Digest Nutrients
Decades of poor dietary practices and environmental degradation have led to a significant loss of critical enzymes in the human gut, limiting our ability to properly digest plant-based foods. This degradation not only robs us of essential nutrients and critically important phytochemicals but also hampers our body’s natural processes.
From a Phytobiogenic perspective, this collapse of digestive capacity is not merely a symptom of modern lifestyles—it is a primary point of causal disruption. When food inputs no longer carry the enzymatic, micronutrient, and signalling complexity they once did, and the body simultaneously loses its capacity to digest and absorb them, a double failure occurs. Nutrients become unavailable just as the systems that rely on them begin to fail.
Restoring these functions isn’t just about eating better—it’s about delivering bioactuated nutrition in a form the body can truly access. This is where Phytobiogenics offers a new way forward: reactivating the dialogue between plant intelligence and human biology to restore homeostasis and resilience from within.
The Foundation of Good Health
Nutrition is essential for all biological processes—not only those linked to growth, development, and energy intake, but also those that determine how resilient we are in the face of stress, infection, and ageing. Immune defence, cellular repair, mental health, brain and body development, hormone regulation, detoxification, and metabolic balance all rely on a steady supply of essential vitamins, minerals, amino acids, and bioactive phytocompounds.
When these inputs are insufficient or poorly absorbed, the body does not fail all at once. It begins to communicate through symptoms: fatigue, brain fog, poor sleep, digestive discomfort, skin problems, blood pressure changes, low mood, and many others. In our work, we view these not as random faults, but as signals that core systems are under strain.
The lack of access to adequate, bioavailable nutrition results in undernutrition, over-nutrition, hidden deficiencies and bioavailability loss, and a rising burden of chronic disease. Food labels may list nutrients, but only a fraction is truly accessible to human biology. Without sufficient and bioavailable co-factors, the enzymes, antioxidant systems, and repair programmes our health depends on cannot operate at full capacity.
True health cannot be restored by simply suppressing symptoms with pharmaceutical agents. Drugs have an essential role, particularly in acute and critical care, but they do not replace the foundational inputs that cells require to function. Our bodies are inherently designed to work with nature to restore equilibrium. When we restore nutritional sufficiency in a form the body recognises, we provide the conditions under which its innate healing capacity can be expressed.
Phytobiogenics: A New Model for Human Health
Phytobiogenics is the scientific framework we are developing at Nutrition Lab Sciences to reconnect human biology with whole-plant intelligence in a precise, measurable way. It begins with a simple premise:
Symptoms are signals. They are the body’s real-time feedback that core systems—cardiometabolic, neurocognitive, immune–inflammatory, detoxification, gut–microbiome, hormonal, structural, and others—no longer have the biological inputs they need to stay in balance—minerals, vitamins, amino acids, co-factors, and phytochemical signalling compounds.
Instead of chasing each symptom in isolation, Phytobiogenics looks at the shared root mechanisms that cut across conditions: redox imbalance, chronic inflammation, mitochondrial fatigue, impaired nitric-oxide signalling, barrier disruption, input depletion, and bioavailability decline.
We have organised this into a 12-system map of human health, supported by more than 60 detailed monographs. On top of this framework, we place Phytobiogenic formulations—whole-plant, bioactuated nutrient matrices designed to act as a daily "signal correction layer" for the body, while also restoring the core foundational biological inputs the body needs to operate, repair, and regulate its internal systems effectively.
Essentbio is the first of these formulations: the world’s first Phytobiogenic.
Our Biocatalytic Breakthrough
To make Phytobiogenics real, we needed a way to transform whole plants into highly bioavailable, synergistic nutrient matrices—without stripping them of their natural intelligence.
We have developed an innovative and proprietary Multi-State Biocatalytic Process that does exactly this. It enhances the nutrient absorption of plant-based foods by liberating essential vitamins, minerals, amino acids, and hundreds of bioactive phytonutrients from the rigid plant cell matrix and holding them in a more bioaccessible, biologically coherent state.
Decades of poor dietary practices and environmental degradation have led to a significant loss of critical enzymes in the human gut, limiting our ability to properly digest plant-based foods. This degradation not only robs us of essential nutrients and critically important phytochemicals but also hampers our body’s natural processes. Restoring these functions isn’t just about eating better—it’s about realigning with nature’s intended balance, allowing us to thrive again.
Our Chief Scientist, Dr. Gustavo Bracho, has worked tirelessly to develop a process that is completely natural, efficient, and scalable—moving more nutrients and compounds from the insoluble matrix into the soluble, absorbable fraction while preserving their native synergy.
This is the technological foundation of Phytobiogenics.
Essentbio - Unlocking the Miracle of Nature
Essentbio is developed from 100% sustainably and organically grown Moringa oleifera leaf and powered by our proprietary Multi-State Biocatalytic Process.
Essentbio transforms this traditional superfood into a next-generation, bioactuated matrix that delivers a coordinated spectrum of essential vitamins, minerals, amino acids, and over 200 naturally occurring bioactive phytocompounds, including polyphenols, isothiocyanates, carotenoids, saponins, and chlorophylls.
In Phytobiogenic terms, Essentbio is designed as a foundational systems-layer: a daily, food-form protocol that supports redox balance, inflammation resolution, mitochondrial energy, vascular function, gut barrier integrity, immune tolerance, and neurocognitive performance across the 12 body systems we map.
Dr. Gustavo Bracho

A Daily Phytobiogenic That Supports Life
As the world’s first Phytobiogenic, Essentbio is more than a supplement; it is a synergistic, sustainable solution that supports the body’s natural ability to restore and maintain optimal health. Delivering bio-enhanced essential nutrients, including proteins, all nine essential amino acids, vitamins, minerals, antioxidants, and phytonutrients—including over 200 bioactive phytocompounds derived from Moringa oleifera—Essentbio also provides critical signalling inputs that help recalibrate biological communication between cells and systems. These signalling compounds play an essential role in restoring function, resolving dysfunction, and guiding the body back toward homeostasis.
Essentbio is provided as a once-daily functional powder using the included dosing scoop. This simple protocol allows people to layer a coherent, essential daily input—providing macro- and micronutrients to fuel biological function, and phytochemical signalling compounds that guide cellular repair, regulation, and adaptation required to restore biological coherence—into their existing routines—supporting multiple systems simultaneously rather than chasing symptoms in isolation.
We are committed to making Essentbio accessible at an affordable price of USD $1 per day, with plans to launch age-appropriate versions, including for children, and to reduce costs further as we scale production.
Native to the Himalayan regions of India, Bangladesh, and Pakistan—and now grown globally—Moringa oleifera is often called the "miracle tree" for its exceptional ability to thrive in diverse conditions and produce leaves with unparalleled nutrient density. With minimal soil and environmental requirements, this versatile tree has immense potential to restore human health on a global scale.
The nutrient-rich leaves of Moringa contain a remarkable concentration of vitamins, minerals, protein, and fibre—making it one of the most nutrient-dense plants on Earth. Its leaves also harbour over 200 bioactive phytocompounds with documented benefits across multiple systems of the body: antioxidant, anti-inflammatory, anti-cancer, glucose and blood pressure regulation, cardiovascular support, cholesterol reduction, detoxification, stress relief, antibacterial, and immunomodulatory effects.
However, much of this potential remains locked within the plant’s insoluble matrix, limiting nutrient absorption—particularly in the context of reduced digestive enzyme capacity in the modern human gut. This is where our Multi-State Biocatalytic Process provides the solution: unlocking the full nutritional and therapeutic potential of Moringa in a form that is truly bioavailable and synergistically active.
Our Vision: Scaling for Global Impact
I believe that nutrition should be universally accessible. Essentbio is more than a supplement—it represents our vision for global health: supporting meaningful, measurable improvement in daily human wellbeing.
Our scalability strategy begins with strategic partnerships and a tightly controlled supply chain, sourcing raw materials from carefully chosen farms and producers worldwide. In parallel, we plan to establish our own farms within the next few years to secure long-term supply integrity and achieve the scale required for real-world impact.
Our goal is to supply tens of thousands of people with Essentbio over the next 12 months, then scale rapidly to reach far more—delivering our Phytobiogenic at a level delivering our Phytobiogenic at a scale capable of reversing current health trends and allowing humanity to heal and thrive.

Launching the World’s Largest Open Cohort Study
To demonstrate Essentbio’s impact, we are planning to launch a groundbreaking open cohort study within the next 3-5 years. This will be the world’s largest study of its kind, providing transparent data on Essentbio’s health benefits.
Call for Partners
Phytobiogenics is not just a scientific breakthrough—it is a global movement. At Nutrition Lab Sciences, we are committed to building a globally accessible, systems-based health solution that reaches communities across every region, income level, and health status. Essentbio represents our first step on this journey.
To make it a reality at scale, we are actively seeking partnerships with governments, NGOs, health foundations, corporate wellness initiatives, national nutrition programmes, and visionary individuals.
With our first biocatalytic processing facility operational and foundational funding secured, we are ready to scale our supply chain, distribution networks, and public health applications. Together, we can reach the populations most affected by hidden hunger and chronic disease, while also supporting the wellness goals of everyday individuals across the globe.
Join us in transforming the future of health through Phytobiogenics.
To explore partnership or strategic collaboration, please contact us at partners@nutritionlab.com.
In Closing
As founder of Nutrition Lab Sciences, I am deeply committed to this mission and confident in the transformative potential of Phytobiogenics—and of Essentbio as its first expression. My vision is simple: that every person, regardless of geography or background, should have access to the biological building blocks required for health, resilience, and human potential.
We now have the science, the process, and the product to make this vision real. But to achieve true impact, it will take a collective effort—a global alliance committed to restoring the conditions for life to thrive.
Be part of the change. Join us as we work to rebuild our health systems from the cellular level up, change global health for good, and catalyse the age of Phytobiogenics.
Faithfully,

Wesley Cooke
Founder and Chief Executive Officer
Nutrition Lab Sciences
References
Nearly 33% of the world’s soil is degraded due to unsustainable farming practices.
- Yale Climate Connections: UN report: The world’s farms stretched to ‘a breaking point’
More than 70% of processed foods contain genetically modified organisms (GMOs).
- Center for Food Safety: About genetically engineered foods
Hundreds of millions of tons of herbicides, pesticides and fertilisers are applied annually, contaminating our soil, air, and water.
- FAO: Inorganic fertilisers
Globally, $1.4 trillion is spent annually on pharmaceutical medications.
- IQVIA: Global use of medicines outlook
Each year, over 1.6 billion Disability-Adjusted Life Years (DALYs) are lost to chronic conditions or Non-Communicable Diseases (NCDs).
- WHO: Global health estimates - Leading causes of DALYs
According to the World Health Organization (WHO), 74% of all deaths result from chronic conditions or Non-Communicable Diseases (NCDs) accounting for over 41 million lives lost every year.
- WHO: Non-Communicable Diseases
More than half the world’s population—approximately 4 billion people—are consuming inadequate levels of critical micronutrients.
Product Disclaimer Statement
Statements regarding Essentbio have not been evaluated by the TGA (Australia), FDA (USA), or EFSA (EU). This product may be categorised as a food, superfood supplement, or dietary supplement depending on country, and is not intended to diagnose, treat, cure, or prevent any disease.